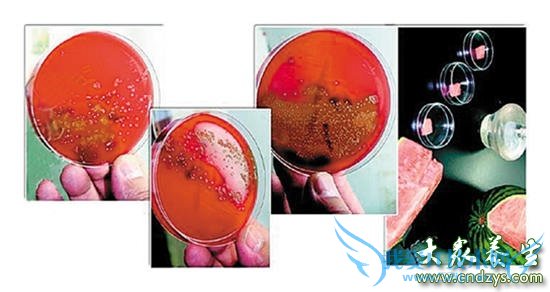
ҹϷŵһڣ(3)

隔夜西瓜放倒一家三口!
欢迎您访问我爱IT技术网,今天小编为你分享的专题是饮食养生方面的知识经验:隔夜西瓜放倒一家三口!,学会并懂得养生才会拥有健康的体魄,下面是详细的分享!
隔夜西瓜放倒一家三口!
天气炎热,很多人喜欢吃冰镇西瓜,并将没吃完的西瓜放在冰箱冷藏,下一顿接着吃。然而,市民丁女士一家却因为吃了过夜的西瓜,一家三口全被放倒。

前一天晚上,丁女士切了一个西瓜,吃剩的一半没舍得扔,封上保鲜膜放到了冰箱里。“感觉放冰箱里又盖上保鲜膜,第二天接着吃应该也没啥问题,可第二天一家人吃后全拉肚子。”丁女士说,第二天中午的时候,把剩下的半个西瓜拿出来晾了晾,午睡后切开一家三口吃了。结果三人闹了一天肚子,“我老公吃得最多,整个人不断往厕所跑,都快虚脱了。”
“去医院拿了些药,发现腹泻的患者真多,聊一聊发现,很多人都是类似原因导致的。”丁女士说,真没想到半个过夜的西瓜这么厉害,以后吃东西可真得注意了。

隔夜西瓜细菌数量以亿计算
西瓜是大家消暑度夏必不可少的水果之一,很多时候,一个大西瓜切开之后吃不完,那么问题来了:几个小时之后,或者隔一个晚上之后,剩下的那一半还能吃么?记者采访中总结出大致三种答案:A直接吃,没问题;B不能吃,直接扔掉;C切掉表面一层再吃。那么这几种做法,那一种更科学,更健康呢?我们通过实验告诉你答案。
6月10晚8点,记者拿出一个事先准备好的西瓜,切掉一半后用保鲜膜包好放在餐桌上。想必这也是大多数人的做法。
6月11日上午7点半点,记者查看了已经放置了一个晚上的西瓜,从表面上看,最外层的西瓜瓤除了稍微有点发干外,似乎并没有什么异样。8点,记者将西瓜送往潍坊医学院附属医院微生物实验室,工作人员将通过检验,看看一个晚上之后,西瓜发生了什么变化。
工作人员分别在西瓜切面的表层、表层下4厘米处、表层下8厘米处取样,每处取样1克,捣碎后放入培养基中,分别标明1、2、3号,放入培养箱。12个小时后,令人震惊的事情发生了。
记者在实验室中看到,1号培养基中分布着密密麻麻的菌落群,就连实验人员也感到吃惊,他们表示其中的细菌数量已经难以数清,需要以亿为单位计算;2号培养基中的菌落群比1号稍微少了一些;3号培养基中菌落群依然很多,也难以计算。而这只是1克样品中的细菌,可想而知整个西瓜中的细菌数量多到何等程度。
通过显微镜观察发现,这些细菌主要有阴性杆菌和阳性球菌,虽然通过肉眼难以观察,但事实却是,数万亿的细菌已经通过西瓜切面渗透到西瓜瓤深深的内部。也就是说,从表面上看起来完好无损的西瓜,实际上已经几乎被细菌占领了。
那么本次实验的结论是,隔夜西瓜,扔掉吧,别觉得可惜。
以上就是关于隔夜西瓜放倒一家三口!的饮食养生专题分享,更多专题请移步到>>专题。
- 评论列表(网友评论仅供网友表达个人看法,并不表明本站同意其观点或证实其描述)
-